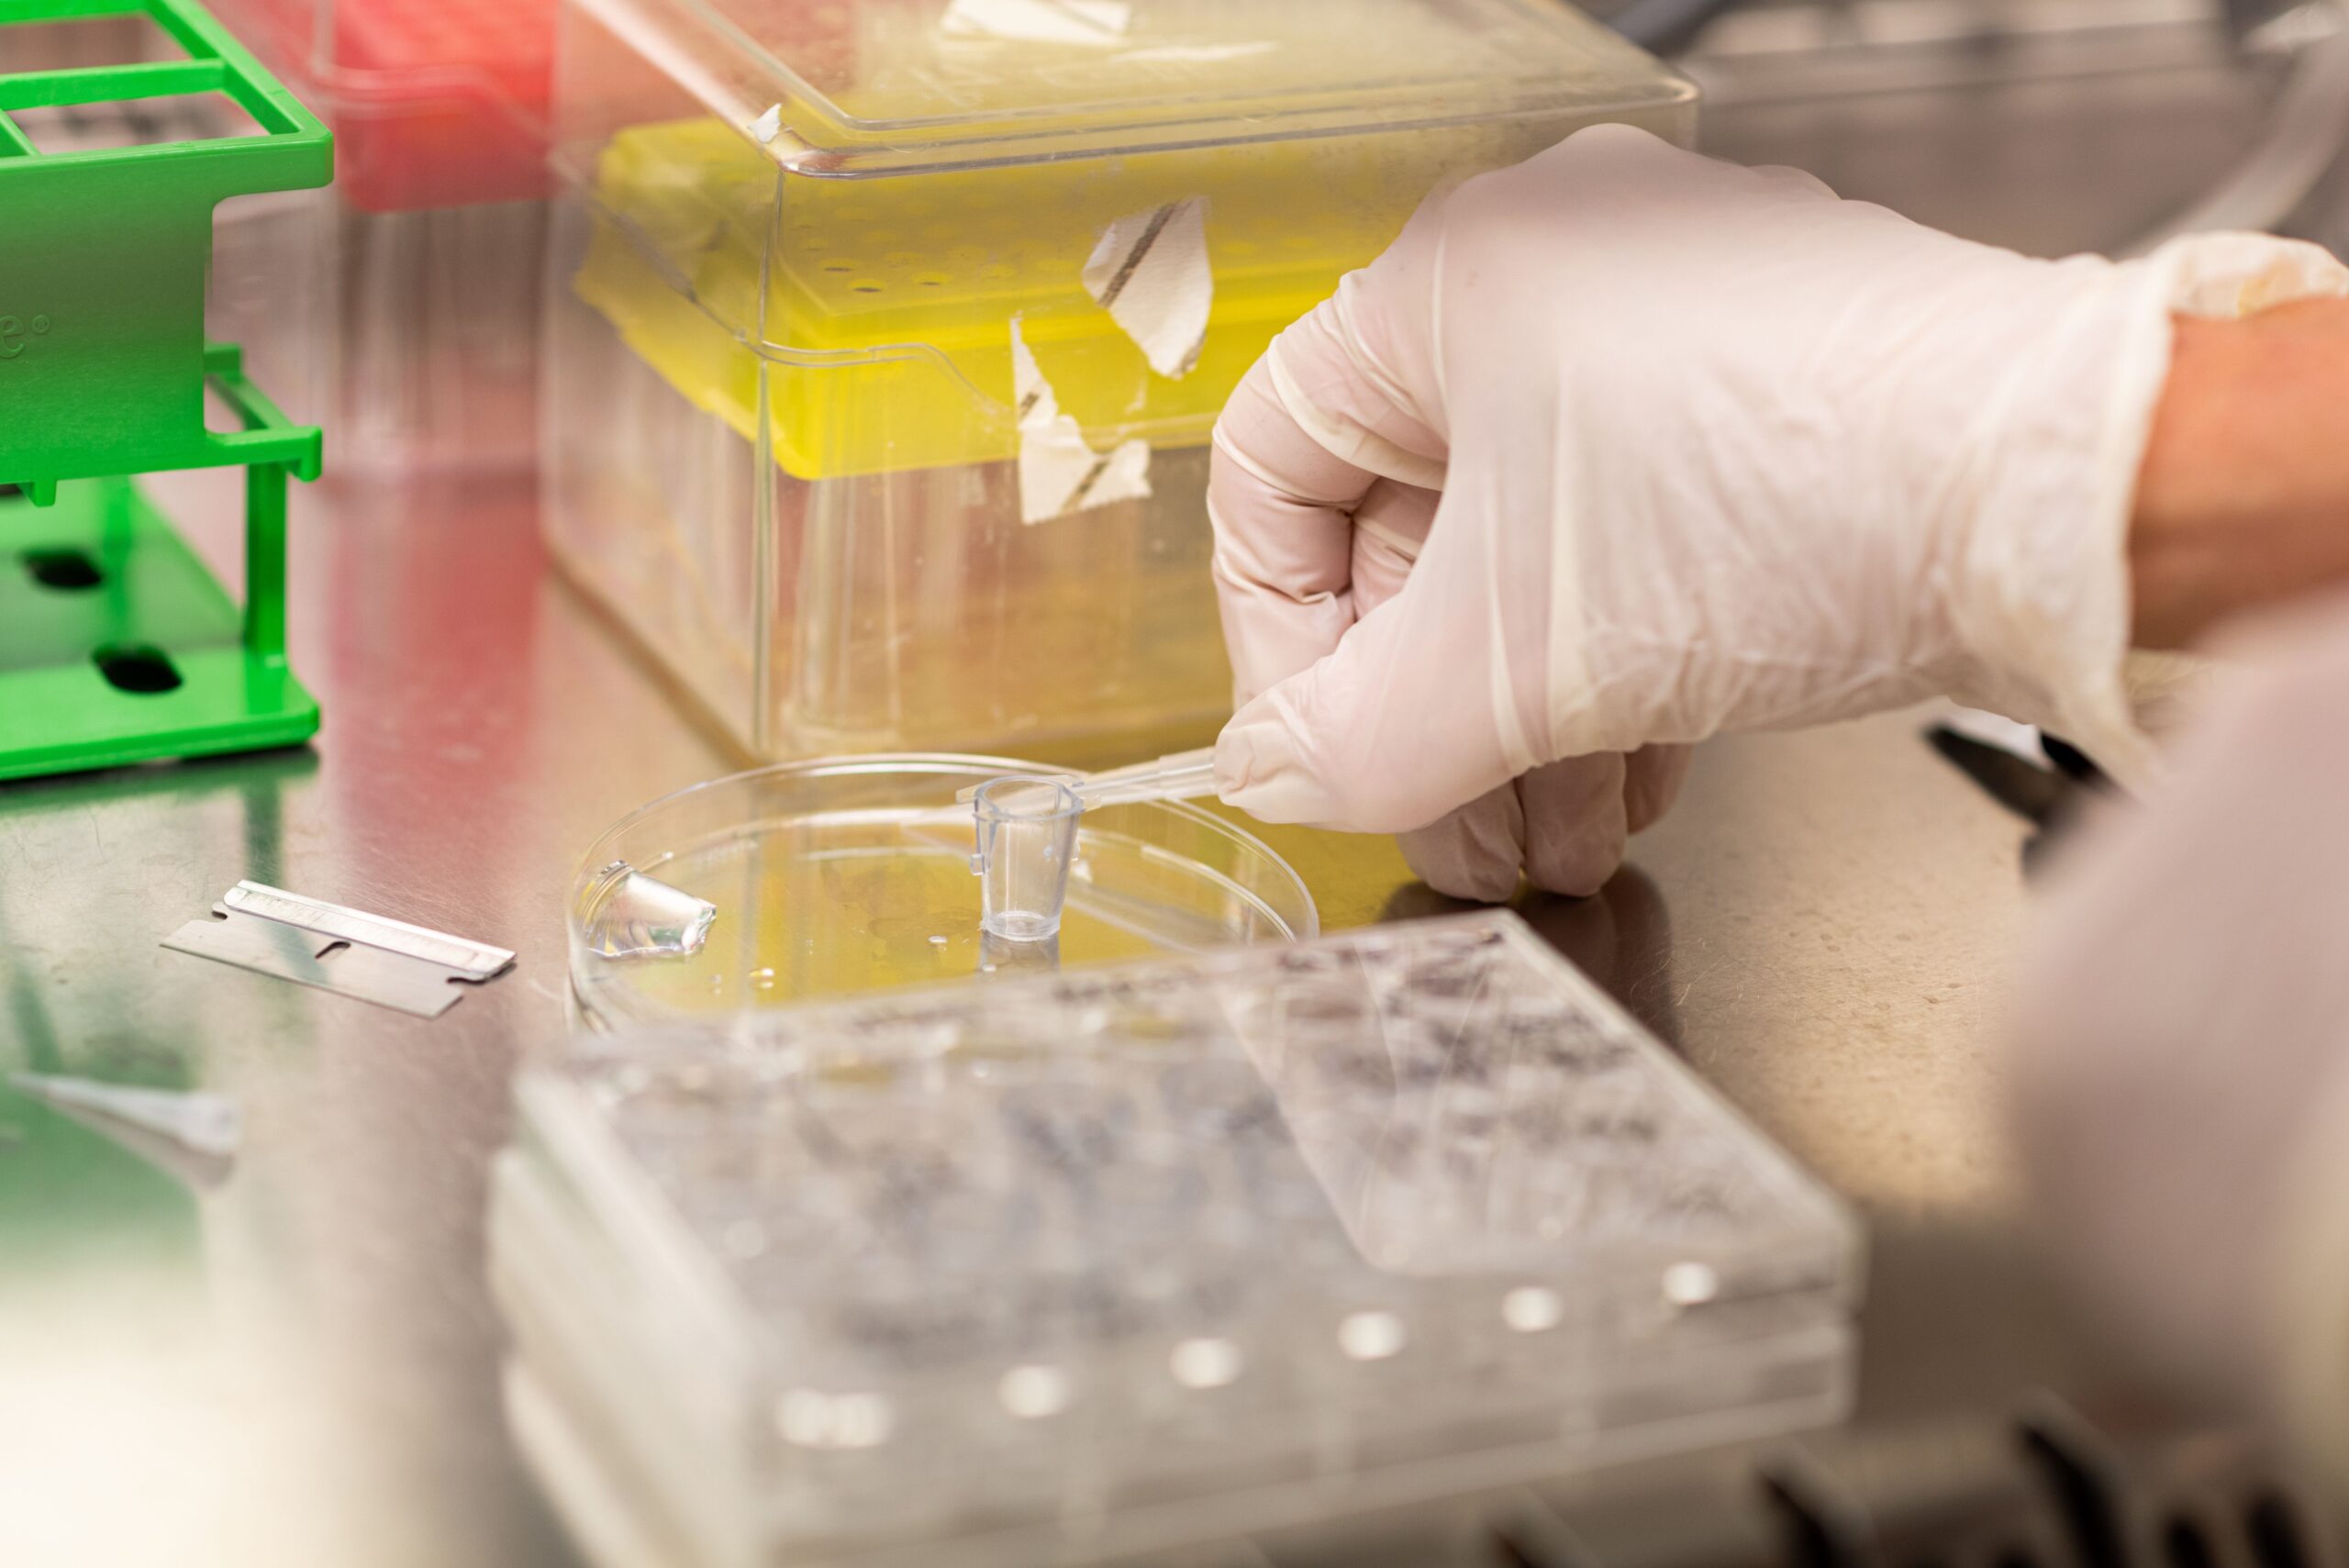

Dierproeven zijn vaak overbodig en soms geven dierproeven zelfs verkeerde inzichten. Mensen zitten immers anders in elkaar dan dieren. Toch worden jaarlijks 450.000 dierproeven gedaan, waarvan 135.000 proeven om de veiligheid van producten te testen voor mensen. Gelukkig biedt een nieuw onderzoeksmodel een oplossing: een computermodel dat dierproeven kan vervangen. Dat steun jij toch ook?
Een computermodel vervangt dierproeven
Een groot aantal Nederlandse wetenschappelijke organisaties laten zien dat het anders kan. Het RIVM en de Universiteit Utrecht, het bedrijfsleven en maatschappelijke organisaties werken samen om het ‘Virtual Human Platform’ te ontwikkelen. Dat is een nieuw computermodel dat gericht is op de mens en waarop we onderzoek kunnen uitvoeren. Door dit computermodel worden proefdieren in de toekomst overbodig én worden onderzoeksresultaten beter vertaalbaar naar de mens. Win-win!
Door dit nieuwe baanbrekende onderzoeksmodel zetten we een grote stap om onze droom uit te laten komen: Een wereld zonder proefdieren. Een droom die jij met een gift kan laten uitkomen!


“We brengen zoveel mogelijk onderzoeksgegevens over eigenschappen van de mens samen in het computermodel. Denk aan data uit ziekenhuizen, van weefselkweken, van grote gezondheidsonderzoeken en uit wetenschappelijke publicaties. Alle data samen bootsen het menselijke lichaam na. Op deze data laten we vervolgens rekenmodellen los die voorspellen welke effecten bepaalde stoffen hebben op de processen in ons lichaam. Dankzij de huidige digitale technieken zijn er nu slimme methoden om dat te doen.”
dr. Anne Kienhuis, RIVM
Steun alternatieven voor dierproeven
Het Virtual Human Platform richt zich in eerste instantie op aangetaste neuronen in de hersenen, nierfalen na een niertransplantatie en de relatie tussen de schildklier en de ontwikkeling van de hersenen. In de toekomst wordt het uitgebreid voor veel meer onderzoeken. Dat is goed nieuws voor mens én dier. Donateurs zoals jij zijn dan ook van onschatbare waarde, want een groot project als het Virtual Human Platform kost veel geld. Om daadwerkelijk stappen te maken richting een proefdiervrije toekomst is jouw hulp hard nodig.
Met jouw bijdrage van 15, 25 of misschien wel 50 euro kunnen wij veelbelovende nieuwe projecten als het Virtual Human Platform blijven financieren.
Samen maken we dierproeven overbodig
Met jouw steun…

… maken we onderzoek beter vertaalbaar naar de mens, zónder dierenleed.